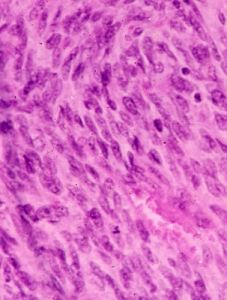
纖維肉瘤 纖維肉瘤

疾病概述
人皮膚纖維肉瘤細胞株這是一種最常見的軟組織肉瘤,以往又名粘液纖維肉瘤,是成纖維細胞的惡性腫瘤,可以產生網狀纖維及膠原纖維。生長緩慢,可發生局部侵襲性生長及復發,晚期才發生轉移。
可發生於任何年齡,但以成年人常見,男女之比為2∶1,好發於四肢長骨的乾骺或骨幹部,以股骨及脛骨為多。
纖維肉瘤主要症狀為疼痛,由輕漸重。周圍型早期可僅有局部腫塊,以後才出現疼痛,中央型發生病理骨折時症狀加劇。中央型惡性程度高,常發生血行轉移,周圍型惡性程度低,很少轉移。一般主要採用手術治療,依腫瘤範圍和臨床生物行為的不同,可作局部大塊切除,節段切除,截肢或關節解脫術。分化差的腫瘤預後極差,因局部手術治療不能取得預期的效果。
病理生理
纖維肉瘤的顯微鏡圖片鏡下可見腫瘤由梭形成纖維細胞組成,交織成鏇渦狀,這些細胞可產生豐富的網狀纖維,有時也能產生粗膠原束。大多數皮膚纖維肉瘤分化良好,產生豐富的纖維組織,很少有絲分裂,未見明顯鏇渦狀結構,而產生纖維少,這些現象表明有侵襲性,預後較差。分化不好的腫瘤細胞有明顯的有絲分裂,但大而不規則的巨細胞或怪細胞則並不常見。腫瘤細胞可侵入血管壁內。分化更差的梭形細胞肉瘤,往往不能分清其組織來源。
纖維肉瘤系來源於口腔頜面部成纖維細胞的惡性腫瘤。以青壯年多見,腫瘤呈球形或分葉狀,發生於口內者,省長較快,多見於牙齦、頜骨;發生於皮膚者可呈結節狀。晚期導致頜面部畸形和功能障礙。還可經血道轉移至肺部。
診斷檢查
纖維肉瘤本病是一種生長緩慢、起源於皮膚並可擴展至皮下組織的局限性低度惡性的纖維肉瘤。 在臨床上出現隆起、硬固纖維性損害,緩慢生長,表麵皮膚萎縮時,可推測為本病,病理中找到緻密的成纖維細胞排列成車輪狀結構,即可確診。本病應與其它起源於深在肌肉組織的軟組織肉瘤區別,通常組織切片可以辨認,但需要作特殊染色。韌帶樣瘤可起源並附著於深在筋膜,表面被有正常皮膚。其它起源於筋膜的纖維瘤病通常可藉助於組織學加以區別,這些腫瘤的間質較細胞成分少,並且無典型的車輪狀結構。偶爾皮膚纖維瘤可有很多細胞,大小可達2~3cm,但幾無車輪狀表現,並有許多含鐵血黃素及吞噬脂質現象。無色素性的惡黑有的需要鑑別,但不大有梭形細胞成車輪狀結構,同時可見交界活躍現象,而且不產生網狀纖維及膠原;新鮮組織可用多巴反應或S—100蛋白免疫組化染色,有助於鑑別。
病狀體徵
肺的纖維肉瘤肉眼見腫瘤為局限性分葉狀硬固結節,切面呈黃褐色或灰白色。位於皮膚,很少侵及深部組織。在同一腫瘤內,組織學表現並不相同。但通常可找到不典型病變,其中成纖維細胞產生網狀纖維,而膠原纖維排列成鏇渦狀或車輪狀,核有絲分裂象少,膠原纖維不多,血管比較豐富,偶見“黃瘤細胞”,真皮乳頭往往受腫瘤侵犯,表皮及附屬器萎縮。細胞的多少及異形程度在腫瘤的不同部位變異很大,有些部位可全部為纖維硬化性。核有絲分裂少見。通常向周圍擴大。復發者更不規則,為多髮結節,比原發者細胞成分多,可以看不到典型緻密的車輪狀結構,大都呈粘液瘤樣。
併發症
本病是一種生長緩慢、起源於皮膚並可擴展至皮下組織的局限性低度惡性的纖維肉瘤。在臨床上出現隆起、硬固纖維性損害,緩慢生長,表麵皮膚萎縮時,可推測為本病,病理中找到緻密的成纖維細胞排列成車輪狀結構,即可確診。易出現血道轉移,橫紋肌纖維增生這些併發症。治療方案
纖維肉瘤治療方案二、採取綜合治療,術前大劑量化療,然後根據腫瘤浸潤範圍作根治性切除瘤段、滅活再植或置入假體的保肢手術,或截肢術,術後繼續大劑量化療。纖維肉瘤肺轉移的發生率極高,除上述治療外,還可行手術切除轉移灶。近年來由於早期診斷和化療迅速發展,纖維肉瘤的5年存活率提高至50%以上。
三、放療質子,纖維肉瘤是一種最常見的惡性骨腫瘤,其特點是惡性瘤細胞直接形成骨樣組織,但腫瘤的成骨過程不明顯者也不能排除排除纖維肉瘤,好發於青少年,好發部位為股骨遠端、脛骨近端和肱骨近端的乾骺端。主要症狀為局部疼痛。多為持續性,逐漸加劇,夜間尤重,並伴有全身惡病質。附近關節功能活動受限。腫瘤表麵皮溫增高,靜脈怒張,紅外線照射時更明顯。溶骨性纖維肉瘤因侵蝕皮質骨面而導致病理性骨折。核素骨現像可以確定腫瘤的大小及發現其他纖維肉瘤灶。
採用傳統X‐ray光子的放射法雖然可以對腫瘤進行打擊,但是放射輻射對兒童的侵害力也是可以看到的.另外,對於纖維肉瘤的根治性手術如果處理不當,也容易對少年患者造成後遺症,因為這些患者的骨骼都是在生長狀態之中的,放射與手術一旦失敗對患者都是難以彌補的創傷.因此,有鑒於此,醫學上目前正積極地利用質子來開展對纖維肉瘤的治療。
健康保健
纖維肉瘤健康保健(1)宜多吃具有抗骨髓病、纖維肉瘤的食物,如海帶、紫菜、淡菜、海蛤、裙帶菜、杏仁、桃仁、李。
(2)骨痛宜吃龜板、鱉肉、穿山甲、牡蠣、蟹、蝦、核桃。
(3)脾臟腫大宜吃甲魚、泥鰍、海鰻、毛蚶、海帶、裙帶菜。
(4)貧血宜吃豬肝、香菇、芝麻、蜂乳、黃魚、花生、海參、鯇魚、鮑魚。
2、忌吃食物:
(1)忌菸酒及辛辣刺激食物。
(2)忌霉變、醃製、油煎、肥膩食物。
(3)忌羊肉、鵝肉、豬頭肉等發物。
預後
纖維肉瘤的預後取決於其組織學的分級和年齡。10歲以下兒童的預後明顯較好。兒童與成人的復發率大致相同,但轉移較少,一般可少於10%。
轉移情況
在成年期,當行邊緣切除或切除範圍不夠廣泛時,常可局部復發。大多數文獻報導其復發率約為50%,而且約60%的病例可發生轉移。當局部復發後,其轉移的發生率也相應增高。一般多轉移到肺、骨骼和肝臟。淋巴轉移者很少(少於5%)。Ⅰ~Ⅱ級的生存率為60%,Ⅲ級和Ⅳ級約為30%。轉移症狀
纖維肉瘤後期會出現轉移,如肺轉移、肝轉移等,當然同時也會伴有相應的纖維肉瘤轉移症狀。如肺轉移患者多會出現咳嗽、痰血、低熱、胸痛、氣悶等,嚴重的話患者會出現面頸部水腫、聲嘶和氣促等症狀。同樣有肝轉移的患者可會出現肝痛、乏力、消瘦、黃疸、腹水等症狀。
常見疾病
| 疾病的存在,是從痛苦和不適等自覺症狀開始的。疾病,有如健康一樣,從不同角度考查可以給出不同的定義。最常套用的定義是"對人體正常形態與功能的偏離。現代醫學對人體的各種生物參數(包括智慧型)都進行了測量,其數值大體上服從統計學中的常態分布規律,即可以計算出一個均值和95%健康個體的所在範圍。 |